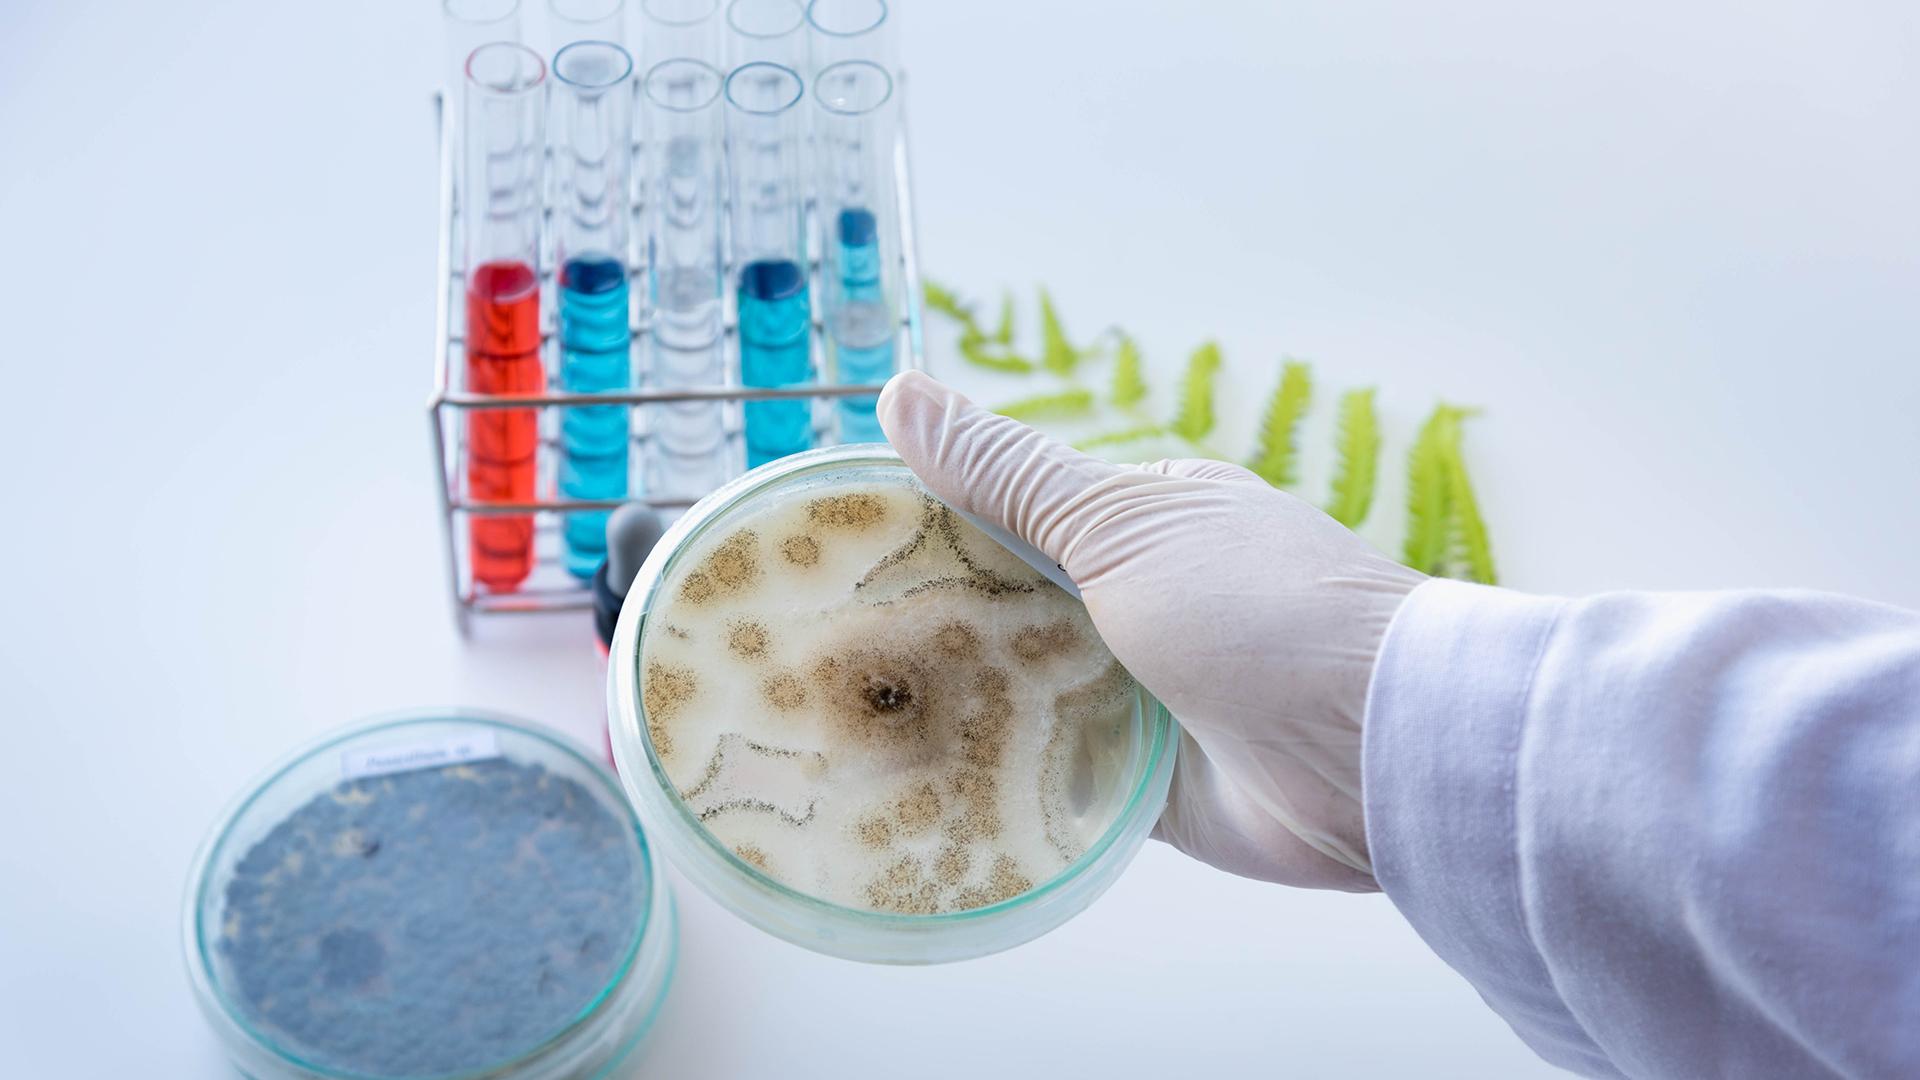
ۆاكتسينا ەل عىلىمىنىڭ بارومەترىنە اينالدى

كوروناۆيرۋس • 27 ءساۋىر, 2021
ۆاكتسينا ادامزاتتى بىرىكتىرەدى
دسۇ شەشىمىمەن 24-30 ءساۋىر ارالىعىندا دۇنيەجۇزىلىك يممۋنيزاتسيا اپتالىعى وتكىزىلىپ جاتىر. «ۆاكتسينا ادامزاتتى بىرىكتىرەدى» دەگەن ۇراندى تۋ ەتكەن اپتالىقتىڭ ماڭىزدىلىعى COVID-19-دىڭ الەمدى شىرماۋىنان بوساتپاي تۇرعان تۇسىندا ودان ءارى ايقىندالا تۇسەدى.
تاريح • 27 ءساۋىر, 2021
قازاق حالقىنىڭ «بالشەبەكتەردەن» كورمەگەنى جوق. اۋەلى كۇشتەپ وتىرىقشى ەتەمىز دەپ قولىنداعى مالىن ءبىر ەمەس, بىرنەشە رەت جيناپ الدى. دىلىنە قيانات جاسادى. رۋحىن جانشىپ, داستۇرىنەن ايىرۋعا بىلەك تۇرە كىرىستى.
مەديتسينا • 27 ءساۋىر, 2021
COVID-19: مۇرىنعا تامىزاتىن ۆاكتسينا
ىندەت ىلمەگىنەن قۇتىلۋدىڭ قامى الەم عالىمدارىن سونى ىزدەنىستەرگە باستادى. بۇگىندە ودان قورعانۋدىڭ امالىندا جاسالعان ۆاكتسينالار 207 مەملەكەتتىڭ ازاماتتارىنا سالىنعان. وسىلايشا, 1 ملرد دوزانى العانداردىڭ 58 پايىزى اقش, قىتاي جانە ءۇندىستان ازاماتتارىن قۇراپتى. بۇل ۆاكتسينانىڭ ەكپە ءتۇرى بولسا, ىزدەنىستى ۇدەتكەن عالىمدار ونىڭ وزگەشە تۇرلەرىن ويلاپ تابۋدا.
تاريح • 23 ءساۋىر, 2021
ۇزىن سالقار تاريح كوشىنىڭ قاي حالىققا دا بەرەتىن ساباعى بار ەكەنى بەلگىلى. جەتەلىلەر تاريحتىڭ قايتالانعانىن كورگەندە, بۇگىنگى تىنىسىندا وتكەننىڭ اششى تۇسىن تۇششىتىپ, كەرمەگىن جۇمسارتىپ, زاپىرانىن ەمدەپ, بولاشاعىنىڭ جارقىن بولۋىنا سولاردى مىسال ەتە وتىرا ۇرپاعىن العا جەتەلەيدى.
مەديتسينا • 20 ءساۋىر, 2021
دۇنيەجۇزىلىك دەنساۋلىق ساقتاۋ ۇيىمى COVID-19-دىڭ الەمگە تاراۋ قارقىنىنىڭ قاۋىپتىلىگىنە الاڭداپ, ازاماتتارعا مەيلىنشە ساقتانۋ قاجەتتىگىن, ال مەملەكەتتەردىڭ جاعدايعا قاراپ شەكتەۋ شارالارىن قاتتى قاداعالاپ وتىرۋىن ۇسىنادى.
كوروناۆيرۋس • 14 ءساۋىر, 2021
جۋىردا دۇنيەجۇزىلىك دەنساۋلىق ساقتاۋ كۇنىندە ددۇ ەۋروپالىق ايماقتىڭ بيۋروسى: «پاندەميا بارلىق ادامزات بالاسىنا اسەرىن تيگىزدى. ءبىرى جاقىنىن جوعالتسا, ءبىرى ونىڭ ەكونوميكالىق زاردابىن كوبىرەك تارتتى, ايتەۋىر ەپيدەميا جولاماي كەتكەن جان جەر جۇزىندە تابىلمايدى», دەپ جازدى.
تاريح • 13 ءساۋىر, 2021
جاسى 95-تەن اسقان كاكەن اپانىڭ قاسىندا ۋاقىتتىڭ قالاي وتكەنىن اڭداماي قالاسىز. اۋلەتىنەن 3 بىردەي جان «حالىق جاۋى» دەگەن جامان اتتى جامىلىپ, ءىز-ءتۇزسىز كەتكەن اكە-اعالارىنىڭ جالعاسىنداي بولىپ وتىرعان كەيۋانا ءومىرى كوپكە وي تاستاعانداي.
مەديتسينا • 07 ءساۋىر, 2021
قان قۇرامىنىڭ سان قىرى اشىلادى
پاندەميامەن كۇرەس كۇللى ادامزات بالاسىن ءتۇرلى ىزدەنىستەرگە باعىتتادى. سونداي سان-سالالى زەرتتەۋگە ۇمتىلعان عىلىمنىڭ ءبىرى – ترانسفۋزيولوگيا.
قوعام • 06 ءساۋىر, 2021
ۆاكتسينا ەل عىلىمىنىڭ بارومەترىنە اينالدى
پاندەميا قۇرساۋى پلانەتانى بوساتار ەمەس. ءۇشىنشى تولقىن دەمىكتىرگەن كارى قۇرلىقتاعى مەملەكەتتەر شارالاردى قاتاڭداتىپ, ۆاكتسيناعا ءۇمىت ارتىپ وتىر. الايدا, ۆاكتسينا بارىنە بىردەي جەتپەي جاتىر.
كوروناۆيرۋس • 06 ءساۋىر, 2021
بۇگىنگى تاڭدا الەم ەلدەرى ۆاكتسينانىڭ 8,6 ملرد دوزاسىن الدىرۋعا شارت جاساسقان دەيدى اقش-تاعى ديۋك ۋنيۆەرسيتەتىنىڭ زەرتتەۋشىلەرى.